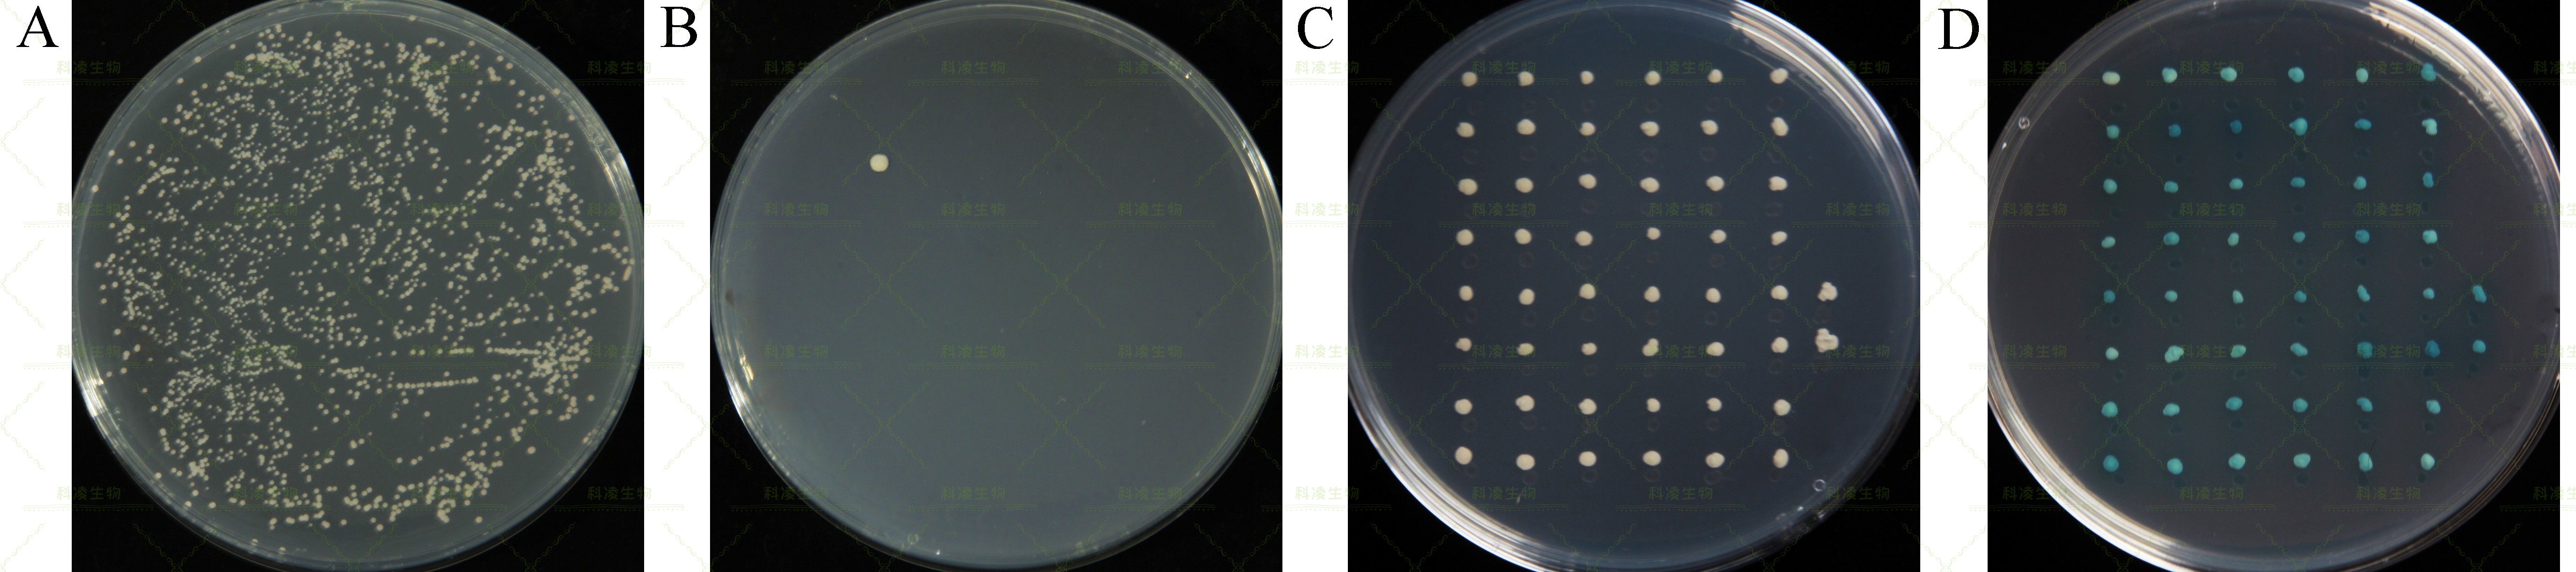
14酵母筛库.jpg

技术服务

技术服务
膜蛋白酵母双杂交系统是将泛素作为降解信号分子来用于膜蛋白之间的互作检测。在膜双杂交体系中,泛素被分为Cub和NubG两个结构域,并在互作检测时各自连接一个目的蛋白。Cub同时连接转录激活因子 LexA-VP16并形成融合蛋白(LexA-VP16是由细菌LexA-DNA结合域和单纯疱疹病毒VP16激活蛋白组成的人工合成转录因子),当两个目的蛋白存在相互作用时,NubG和 Cub 在空间上相互接近并形成完整的泛素分子,导致转录激活因子LexA-VP16被泛素专一性蛋白酶(UBPs)切割,游离的LexA-VP16进入细胞核后激活报告基因His3,Ade和LacZ的转录与表达。因为膜杂交系统的正常运行需要bait(Cub-LexA-VP16)和prey(NubG)位于胞浆中,因此不同的蛋白需要选择合适的载体。原理图如下:

筛选与目的蛋白互作的未知蛋白。
1、自研不同植物及多糖多酚RNA提取试剂盒,保证RNA高提取量及完整性;
2、高质量的mRNA纯化技术,保证后续高库容(1*107次方);
3、Gateway构建方法,确保文库基因均一化,且无冗余;
4、文库构建过程无PCR过程确保平均插入片段超过1kb。
建库:咨询下单—植物材料寄送—文库构建—质检—结果交付;
筛库:诱饵确认—载体构建—文库筛选—结果交付。
标准实验报告,包括实验步骤与结果;
建库产品:1、初次级文库甘油菌各 4 ml;2、初次级文库质粒各200 μg;
筛库:50个阳性克隆的PCR测序,超过50个克隆部分为40元/克隆测序;
建库和筛库过程的图片(单反拍照)。
建库实验组织样本需要干冰寄送,且质量不少于10g;
载体需要新鲜或甘油菌液体积大于0.5 ml,冰袋运输;
质粒 DNA 体积大于20 μl,浓度不低于30ng/μl,,且主带明显无降解;
提供测序结果以及抗性;
如需我司构建载体,要求详见载体构建。
结果初析:诱饵质粒和文库质粒共转化酵母细胞后二缺(-Leu-Trp)平板上检测转化效率(A),高转化效率保障诱饵和文库所有基因表达质粒成功转化进入酵母。转化后酵母细胞涂布100个四缺平板(-Leu-Trp-His-Ade)并进行筛选(B),此时每个平板上会长出个别阳性克隆。将筛选平板上克隆转移至四缺和含有x-a-gal的平板上(C,D),正常生长和显色的克隆可以判断为互作情况。最后,PCR得到文库质粒中的片段并测序,数据库比对得到互作候选基因。

结果初析:互作候选基因扩增全长并重新构建载体,回转验证互作情况。结果显示,仅有部分序列可正常与诱饵互作,其余序列均无法互作。回转点对点验证成功的可用于后续基因功能的研究。
